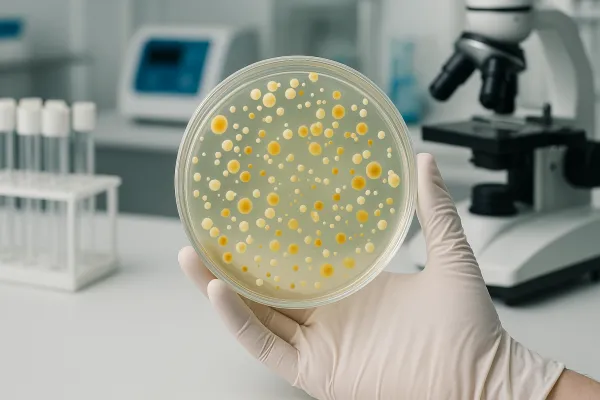

توکسین باکتری چیست؟
توکسین باکتری چیست؟ توکسین باکتری یا سم باکتریایی، ترکیب زیستی فعالی است که توسط برخی باکتریها تولید و ترشح میشود و میتواند بر سلولها و بافتهای موجودات زنده اثرات زیانبار

توکسین باکتری چیست؟ توکسین باکتری یا سم باکتریایی، ترکیب زیستی فعالی است که توسط برخی باکتریها تولید و ترشح میشود و میتواند بر سلولها و بافتهای موجودات زنده اثرات زیانبار
تست افتراقی چیست؟ تست افتراقی (Tests for Specified Microorganisms) طبق USP 〈62〉 برای بررسی وجود یا عدم وجود میکروارگانیسمهای مشخص را در نمونه های غیراستریل و برای جستوجوی ارگانیسمهای مشخص

در کلینرومهای صنایع دارویی، تجهیزات پزشکی،بیمارستان ها و درمانگاه ها، هر میزان آلودگی یا میکروارگانیسم می تواند پیامدهای جدی بر کیفیت محصول و ایمنی بیمار داشته باشد. به همین دلیل

آزمون اندوتوکسین در آب های RO، DI و WFI در صنایع دارویی و پزشکی اهمیتی حیاتی دارد، زیرا این آبها بهعنوان پایه اصلی در تهیه داروهای تزریقی، محلولهای همودیالیز و

آزمایشگاه همکار غذا و دارو تهران نیکوفارمد آزمایشگاه همکار غذا و دارو نیکوفارمد با دریافت مجوزها و تأییدیههای معتبر از سازمان غذا و دارو، سازمان ملی استاندارد ایران، اداره کل

آزمایشگاه همکار نیکوفارمد با اخذ گواهینامههای معتبر از سازمان غذا و دارو، سازمان ملی استاندارد ایران (ISO/IEC 17025)، اداره کل تجهیزات و ملزومات پزشکی و همچنین سازمان دامپزشکی کشور، بهعنوان
تلفن : 02144182873 – 02191309890 – 02144184570
مشاوره و پذیرش: 09926062450
پیگیری نتایج: 09918126355
ایمیل : nikopharmed@gmail.com
تهران، منطقه 22 ، ورداورد، بلوار پژوهش، پژوهشگاه ملی مهندسی ژنتیک و زیست فناوری، طبقه منفی یک، شرکت نیکوفارمد آریا
کدپستی: 1497716316
© تمام حقوق این سایت متعلق به آزمایشگاه نیکوفارمد میباشد.